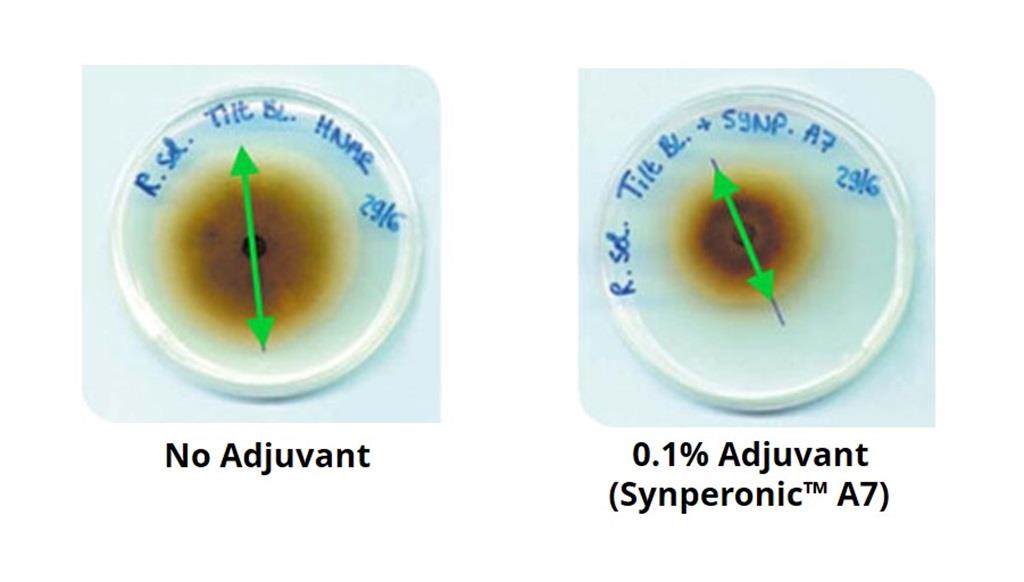

Adjuvants for fungicides
Adjuvants play an essential role in increasing the biological efficacy of agrochemicals. The role of adjuvants in herbicide formulations is relatively easy to understand since herbicides must always penetrate the weeds to have an effect. Physiochemical factors (such as spray adhesion, spray retention, wetting and spreading) and systemic factors (such as uptake of the active ingredient) determine the efficacy of a herbicide.

With fungicides, the situation is more complicated. The fungicide can be active against the fungal spores on the leaf’s surface, as well as active inside the leaf’s cells. Using an adjuvant introduces another factor in the interaction between the fungus, fungicide, and host plant. The selection of an adjuvant can enhance the uptake and transport of the fungicide spray solution into the cell wall of the fungus. It is this fungicide-adjuvant interaction that makes the selection of an adjuvant specific for a particular fungicide and fungus disease. We have developed a range of products specifically to deal with the issues of fungicide formulations. Our adjuvants balance the two driving factors of formulation stability and fungicide efficacy. Our latest development in this technology has seen us add Atplus™ PFA to our portfolio. Atplus PFA is a pourable adjuvant that aids and intensifies the action of fungicides, especially against soybean rust disease (Phakopsora pachyrhizi).
The graph shows the performance of Atplus PFA in combination with a commercial fungicide (active ingredient: azoxystrobin) for the control of Asian soybean rust (Phakopsora pachyrhizi). It shows that using Atplus PFA improves fungicide performance as the percentage of fungi remaining on the leaf after treatment has been reduced.
Adjuvants for Fungicide Datasheet
The image is an example of the effect of another adjuvant in our range. Both plates have been seeded with mycelium of Rhizoctonia solani and treated with 1ppm of Tilt EC. The plate on the right has been treated with 0.1% adjuvant (Synperonic™ A7) whereas the plate on the left has not. The effect of the adjuvant is clear, having inhibited the growth of the fungus by 50%.


